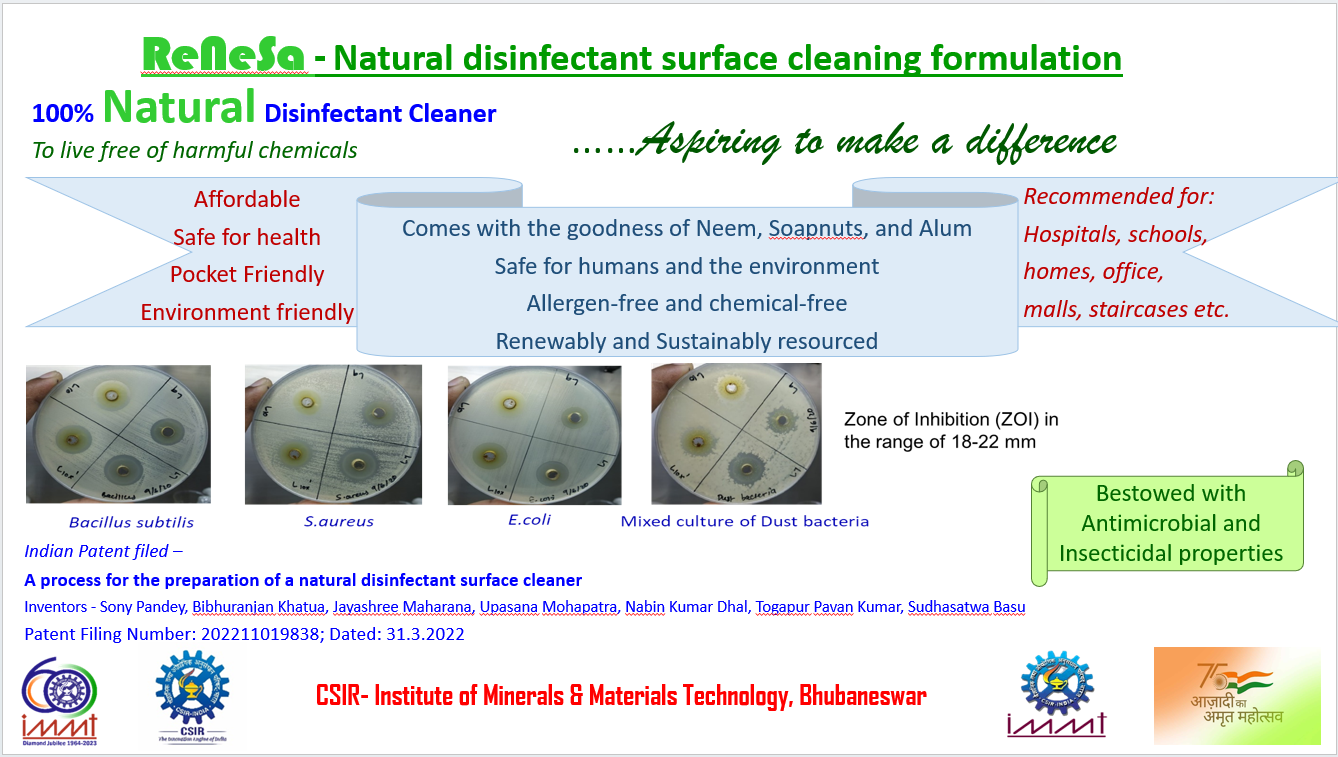

View Project
Scale-up and Commercialization of ReNeSa: Sustainable Natural Surface Disinfectant for a Safer Tomorrow.
Status: New
Lab/Organization
| Name & address of the Laboratory/Organization | CSIR-Institute of Minerals and Materials Technology (IMMT) | |
| Website address | www.immt.res.in | |
| Affiliated to which Department/Ministry | Council of Scientific and Industrial Research (CSIR) | |
| CSR Registration Number | CSR00017422 | |
| Registration under 12A | ||
| Registration under 80G | ||
| Name of the CSR Nodal | Dr. Pavan Kumar | |
| Contact information of CSR Nodal | 08008105781, pavantogapur@immt.res.in | |
| Principal Investigator | Dr. Sony Pandey , sony@immt.res.in | |
| Co- Principal Investigator (Co-PI) | ||
Project Detail
| Objective on the basis of need | Sanitation and hygiene is of paramount importance in the era of the pandemic and beyond. Pandemics just underscore the need for such products. The surface cleaning products market is predicted to grow very fast in the next ten years, and the demand for bio based safe natural products is only increase with time. Consumers are now more aware of toxic chemical-based products' impact on health and environment. |
| Executive summary of the proposed project (In 250 words) | The need of cheap and abundantly available antimicrobial cleaning solutions was underlined by the pandemic, but it will continue to remain of great importance to clean frequently touched/used surfaces for all times to come. There are a variety of cleaning solutions available in the market that can be used for this purpose but they are costly and toxic to the human and environment. Here we present an easy method of preparing a natural antimicrobial solution which can effectively clean any surface including the floor, with raw materials that are inexpensive and abundantly available. The simple natural ingredients like lemongrass or neem etc. used in a specific proportion, method and combinations produces powerful antimicrobial action. This is an environment friendly and skin safe option for disinfection of indoor places like doors and windows, handles, working tables, chairs, lobbies, corridors, staircase railing, escalators, elevator, offices, hospitals, public service booths etc. which is required to be cleaned on a regular basis. Antimicrobial tests have been carried out extensively against gram negative and gram positive bacteria and mixed culture of bacteria from dust and air by agar well diffusion method and surface swab test method, and significant reduction of bacteria was found on the surfaces. The formulation is extremely effective disinfectant, in comparison with the currently available popular brands of chemical and herbal disinfectant surface cleaners in the market. It works well with dilutions up to 250 times and the results show that this formulation works at par with the commercially available brands. |
| Technology Readiness Level (If not a new project but an advancement of existing know how) | TRL-6 |
| Outomes or Deliverables | A natural, non-toxic, and affordable disinfectant surface cleaner that is Safe for us, Safe for the Planet to shape a better tomorrow is being proposed. |
| Project aligned with which most relevant UN SDGs | Goal 3 - Good Health & Well-Being Goal 6 - Clean Water & Sanitataion Goal 9 - Industry, Innovation & Infrastructure Goal 11 - Sustainable Cities & Communities Goal 12 - Responsible Consumption & Production |
| Duration (In years) | One year |
| Expected Impact | Industry - There are many disinfectant surface cleaning products available in the market but they contain harsh chemicals that are not good for the environment. This natural disinfectant surface cleaner can be made at a very low cost and shows antimicrobial properties at par with the commercially available brands. This product will have a market edge because of its non-toxic nature. The consumers today are aware and conscious of the health and environment therefore such products are expected to have a huge impact on the market and the FMCG/surface cleaner industry as well. The greatest advantage of this product is that it can be easily made with inexpensive equipment in a co-operative business model, or a collaborative business model with the rural women self-help groups and achieve a huge socioeconomic impact. Quality of life definitely improves with such safe and inexpensive products that provide protection to the human and pets’ population from acquiring infections. |
| Implementation model (self- implemented/ outsourced partnership) | Outsourced Partnership |
| Total Budget (Recurring +Non-Recurring Expenses) | Rs. 50,00,000 (Rs. 30,00,000 + Rs. 20,00,000) |